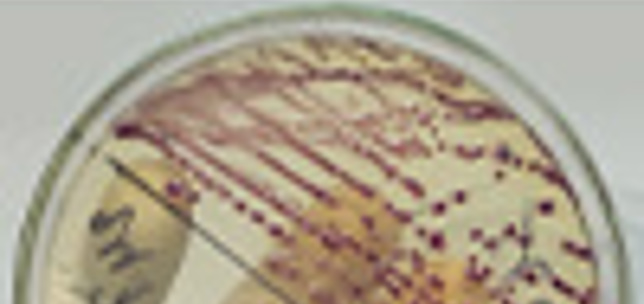

The British Association of Urological Nurses (BAUN) Conference 2024 takes place from 4-5 November at the ACC in Liverpool. In addition, popular pre-conference workshops are taking place on Sunday 3 November.
The Urology Foundation is delighted to announce the first grant call of our Urinary Tract Infections Research Initiative. Applications are invited for research projects into Urinary Tract Infections (UTIs) worth up to £250,000.

This recent update provides increased access to the AngioDynamics NanoKnife IRE ablation...

LoFric® Origo is a user-friendly and safe male hydrophilic catheter. It comes in a discreet, foldable package that easily fits in a pocket.

Team iMEDicare Execs will climb the tallest mountain in Poland (Mount Rysy in the Tatra Mountains – 8,199 feet/2,499 metres), on the 27th of August 2023.

Female fluoroscopy procedures including Hysterosalpingography (HSG) to assess uterine cavity and fallopian tubes, as well as video...

Despite the rumours of Contiform’s demise that have been greatly exaggerated, and that...

Men’s Liberty™ is the innovative alternative to traditional male external catheters.



